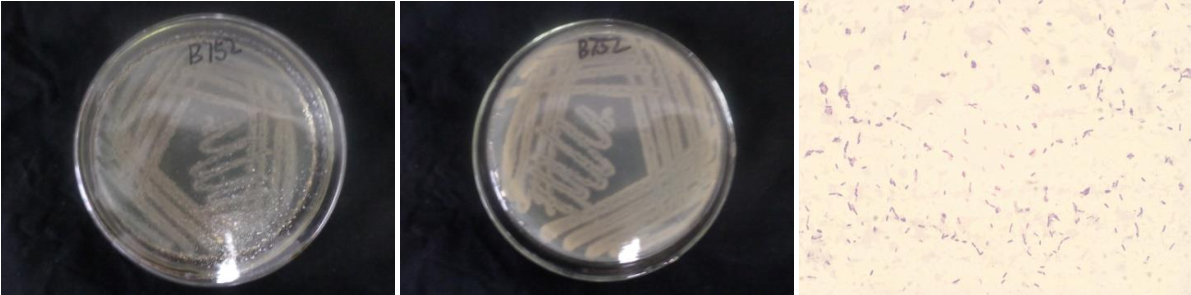

Loading...
| StrainNO | B752 |
| Classification | Bacillus |
| 16s rDNA sequence | GGCGGCTGGCTCCAAAAGGTTACCTCACCGACTTCGGGTGTTACAAACTCTCGTGGTGTGACGGGCGGTGTGTACAAGGCCCGG GAACGTATTCACCGCGGCATGCTGATCCGCGATTACTAGCGATTCCAGCTTCACGCAGTCGAGTTGCAGACTGCGATCCGAACT GAGAACAGATTTGTGGGATTGGCTTAGCCTCGCGGCTTCGCTGCCCTTTGTTCTGCCCATTGTAGCACGTGTGTAGCCCAGGTC ATAAGGGGCATGATGATTTGACGTCATCCCCACCTTCCTCCGGTTTGTCACCGGCAGTCACCTTAGAGTGCCCAACTGAATGCT GGCAACTAAGATCAAGGGTTGCGCTCGTTGCGGGACTTAACCCAACATCTCACGACACGAGCTGACGACAACCATGCACCACCT GTCACTCTGCCCCCGAAGGGGAAGCCCTATCTCTAGGGTTGTCAGAGGATGTCAAGACCTGGTAAGGTTCTTCGCGTTGCTTCG AATTAAACCACATGCTCCACCGCTTGTGCGGGCCCCSGTCAATTCCTTTGAGTTTCAGTCTTGCGACCGTACTCCCCAGGCGGA GTGCTTAATGCGTTTGCTGCAGCACTAAAGGGCGGAAACCCTCTAACACTTAGCACTCATCGTTTACGGCGTGGACTACCAGGG TATCTAATCCTGTTCGCTCCCCACGCTTTCGCGCYTCAGCGTCAGTTACAGACCAGAGAGTCGCYTTCGCCACTGGTGTTCCTC CACATCTCTACGCATTTCACCGCTACACGTGGAATTCCACTCTCYTCTTCTGCACTCAAGTTCCCCAGTTTCCAATGACCCTCC CCGGTTGAGCCGGGGGCTTTCACATCAGACTTAAGAAACCGCCTGCGCGCGCTTTACGCCCAATAATTCCGGACAACGCTTGCC ACTTACGTATTACCGCGGCTGCTGGCACGTAGTTAGCCGTGGCTTTCTGGTTAGGTACCGTCAAGGTACCGCCCTATTCGAACG GTACTTGTTCTTCCCTAACAACAGAGTTTTACGATCCGAAAACCTTCATCACTCACGCGGCGTTGTTCCGTCAGACTTTCGTCC ATTGCGGAAGATTCCCTACTGCTGCCTCCCGTAGGAGTCTGGGCCGTGTTTCAGTCCCAGTGTGGCCGATCACCCTCTCAGGTCGGCTACGCATCGTCGCCTTGGTGAGCCGTTACCTCACCAACTAGCTAATGCGCCGCGGGTCCATCTGTAAGTGGTAGCTAAAAG CCACCTTTTATGATTGAACCATGCGGTTCAATCAAGCATCCGGTATTAGCCCCGGTTTCCCGGAGTTATCCCAGTCTTACAGGC AGGTTACCCACGTGTTACTCACCCGTCCGCCGCTGACCTAAGGGAGCAAGCTCCCGTCGGTCC |
| Strain Morphology Photos | |
| Morphological Description | The morphology of Colony round;clam white;feathered edges;edge bumps;concentric ring;wrinkled;slippy;sticky;waxy;The morphology of strain:Rod;having spore;bias in budding spores |